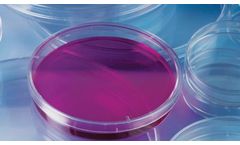
Omark - Model OMK-PD9016 - Petri Dish

- Home
- Equipment
Refine by
Omark Environmental Equipment & Supplies
9 equipment items found
Manufactured by:OMARK Lifesciences Pvt Ltd based inNoida, INDIA
LDPE Wash Bottle Ideal for Distilled ...
Manufactured by:OMARK Lifesciences Pvt Ltd based inNoida, INDIA
Omark Consumables manufactures Ria Tubes using Medical Grade Polystyrene (PS).Ria Vials are also called Ria Tubes or Test Tubes 12 X 75 ...
Manufactured by:OMARK Lifesciences Pvt Ltd based inNoida, INDIA
These bottles come with inner thread for superior sealing and better security. These bottles are used for packing, shipping and storage ...
Manufactured by:OMARK Lifesciences Pvt Ltd based inNoida, INDIA
Omark Spatula is moulded in ...
Manufactured by:OMARK Lifesciences Pvt Ltd based inNoida, INDIA
Our Separatory funnel is moulded from high quality virgin Polypropylene to ensure excellent clarity and ...
Manufactured by:OMARK Lifesciences Pvt Ltd based inNoida, INDIA
Petri Dish ( PS) , 90 x 15 mm, 3 Vents, Sleeves of 10, Gamma Sterile ...
Manufactured by:OMARK Lifesciences Pvt Ltd based inNoida, INDIA
Petri Dish ( PS) , 90 x 15 mm, 3 Vents, Sleeves of 10, Aseptic . ...
Manufactured by:OMARK Lifesciences Pvt Ltd based inNoida, INDIA
Moulded from high quality virgin low-density polyethylene to ensure excellent ...
Manufactured by:OMARK Lifesciences Pvt Ltd based inNoida, INDIA
Retort stand side hole ...